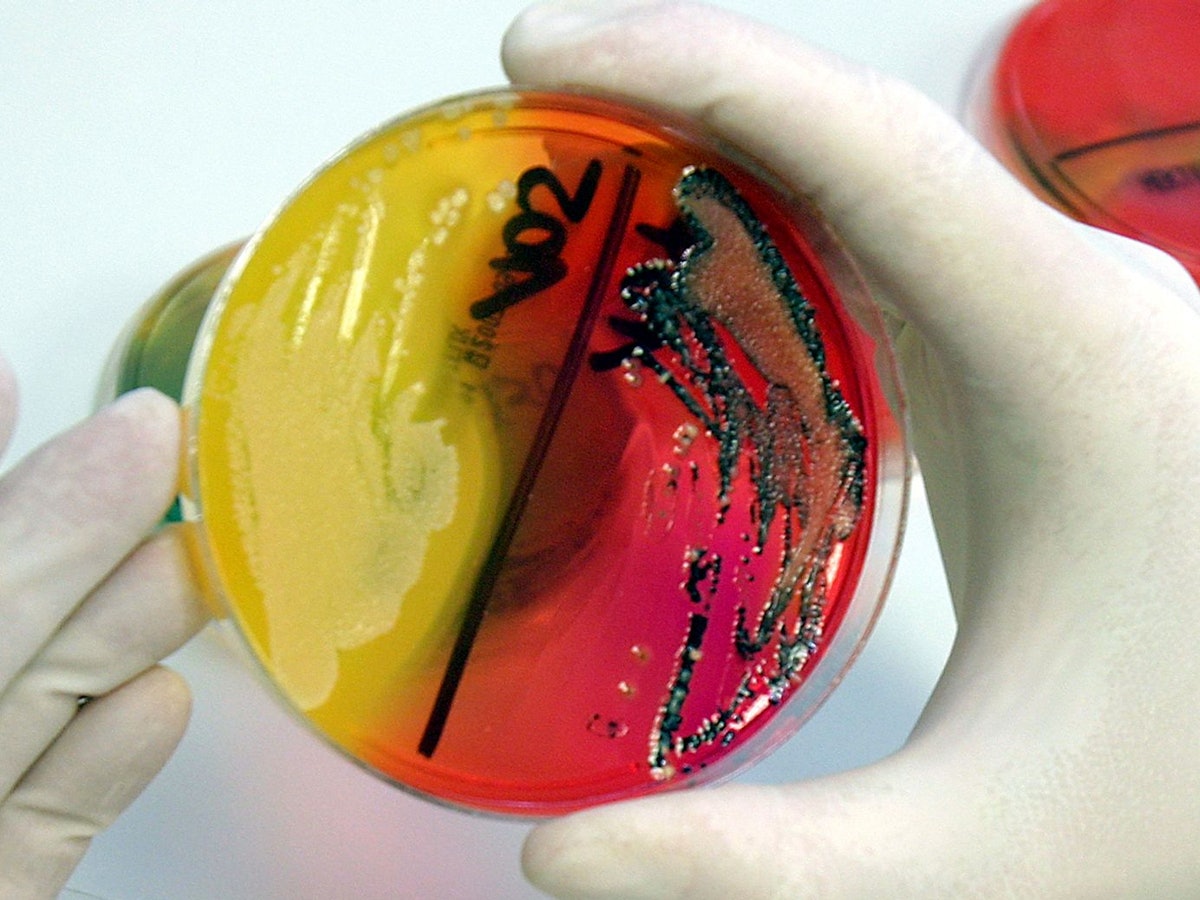
22.05.2007 in Fulda: Eine Labor-Mitarbeiterin zeigt eine Petrischale mit einer Salmonellenkultur.

Achtung, diese beliebten dm-Produkte können für manche Menschen gefährlich werden: Verbraucher sollten nachschauen, ob der Artikel nicht vielleicht bei ihnen im Schrank steht, denn verwendet werden soll er definitiv nicht.
Großer Rückrufdm-Produkte betroffen: Vorsicht vor gefährlichen Keimen

Copyright: picture alliance / dpa
Gleich zwei Produkte des Drogerie-Riesen dm, hier ein Foto aus einer Filiale in Karlsruhe von 2015, wurden zurückgerufen, weil es gefährliche Keime enthält.
Aktualisiert
Köln. Vor allem im Sommer benutzen es viele. Doch jetzt könnte die Verwendung für manche gefährlich werden. Ein beliebtes Balea-Produkt wurde zurückgerufen, weil es gefährliche Keime enthält. Das stellte sich in mehreren Eigenversuchen heraus.
Betroffen ist das „Balea Wasserspray AQUA“ in den Größen 150 ml und 75 ml. Es sind also gleich zwei Produkte, die zurückgerufen werden.
Was ist das Problem? Die darin gefundenen Keime können vor allem für Menschen mit Atemwegserkrankungen sehr gefährlich werden.
Rückruf bei dm: Gefährliche Keime in Wasserspray von Balea
Laut „produktwarnung.eu“ kann nicht ausgeschlossen werden, dass das „Balea Wasserspray AQUA“ von dm mikrobiologisch belastet ist. Erschreckend: Es sind alle Produkte betroffen, der Rückruf bezieht sich nicht nur auf einzelne Produkte.
Das Produkt weist nämlich die Bakterien Burkholderia cenocepacia sowie Ralstonia pickettii auf. Doch was was sind das für Bakterien und warum sind sie gefährlich?
Bei Burkholderia cenocepacia handelt es sich laut „DAZ.de“ um ein Stäbchenbakterium, das vor allem im Krankenhaus großen Schaden anrichten kann, denn bei Immungeschwächten Menschen oder empfindlichen Verbrauchern können die Keime eine Infektion auslösen. Für gesunde Menschen stellen die Keime glücklicherweise kein hohes Risiko dar, das Risiko einer gesundheitlichen Auswirkung ist gering.
Rückruf: Umtausch vom „Balea Wasserspray AQUA“
Doch in welchen Bundesländern ist das Produkt erhältlich? Und was soll ich tun, wenn ich es besitze? Kann ich das „Balea Wasserspray AQUA“ auch umtauschen, wenn ich es schon angebrochen habe? Laut „lebensmittelwarnung.de“ sind folgende Bundesländer betroffen:
- Nordrhein-Westfahlen
- Baden-Württemberg
- Bayern
- Berlin
- Brandenburg
- Hessen
- Mecklenburg-Vorpommern
- Rheinland-Pfalz
- Saarland
- Sachsen
- Sachsen-Anhalt
- Schleswig-Holstein
- Thüringen
Wer im Besitz eines Balea Wasserspray AQUA ist, soll das Produkt nicht verwenden.
Stattdessen soll es in dem dm-Markt, in dem der Artikel gekauft wurde, direkt umgetauscht werden. Daraufhin wird der Kaufpreis erstattet. Auch bereits angebrochene Produkte werden angenommen. Ein Kassenbon ist nicht notwendig, das Geld wird problemlos ausgezahlt. (sai)